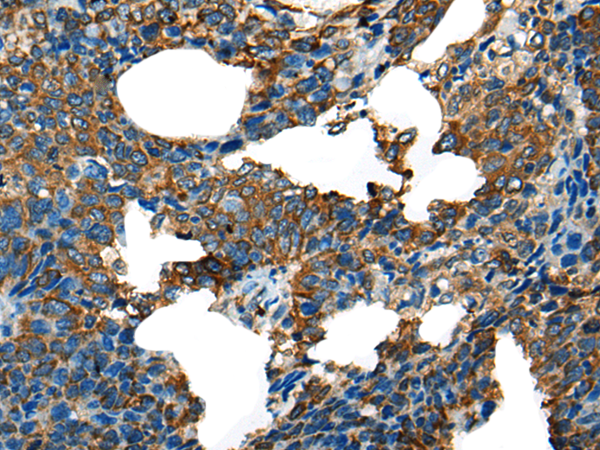
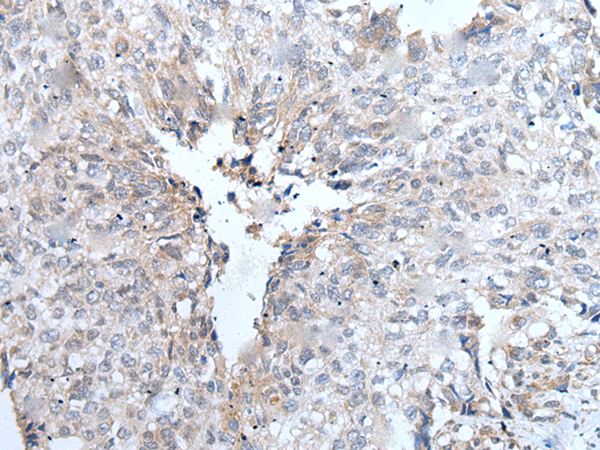

-
分类: 科研抗体货号: P12859别名: YB1; BP-8; CSDB; DBPB; YB-1; CBF-A; CSDA2; EFI-A; NSEP1; NSEP-1; MDR-NF1应用: IHC反应种属: Human, Mouse, Rat
-
分类: 科研抗体货号: P12855别名: LRPDIT; LRP-DIT应用: IHC反应种属: Human, Mouse
-
分类: 科研抗体货号: P12875别名: DR11; HH14; BRWD2; WDR15应用: WB,IHC反应种属: Human
-
分类: 科研抗体货号: P12854别名: JEDI; MEGF12应用: IHC反应种属: Human, Mouse
-
分类: 科研抗体货号: P12894别名: VCX1; VCXB1; VCX-B1; VCX10R; VCX-10r应用: IHC反应种属: Human
-
分类: 科研抗体货号: P12874别名: AND1; CTF4; AND-1; CHTF4应用: IHC反应种属: Human
-
分类: 科研抗体货号: P12853别名: TX; Mih1; ICH-2; Mih1/TX; ICEREL-II; ICE(rel)II应用: IHC反应种属: Human
-
分类: 科研抗体货号: P12893别名: MCOPS11应用: IHC反应种属: Human, Mouse, Rat
-
分类: 科研抗体货号: P12873别名: C35; ORB3; XTP4; RDX12; C17orf37应用: IHC反应种属: Human, Mouse
-
分类: 科研抗体货号: P12851别名: AMOG应用: WB,IHC反应种属: Human, Mouse, Rat

鄂公网安备42018502007531号
鄂公网安备42018502007531号

